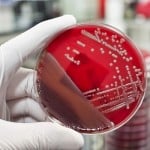

Home Search
cancer - search results
If you're not happy with the results, please do another search
Combing the Genome for the Genetics behind Hair Color
Combing the Genome for the Genetics behind Hair Color
Happen to love your hair color? Or maybe not? Whatever your inclination, here are exactly 124...
CRISPR Undergoes Dramatic Improvement by Guide Molecule Replacement
CRISPR Undergoes Dramatic Improvement by Guide Molecule Replacement
More than ever, we can view the genomes of humans and other organisms as drafts—not final and...
Estonia Launches First State-Sponsored Genetic Testing for Residents
Estonia Launches First State-Sponsored Genetic Testing for Residents
The Estonian government has now chalked up plans to provide free DNA-based lifestyle advice for 100,000 of...
Protein-Overwhelmed Mitochondria Resorts to MitoCPR
Protein-Overwhelmed Mitochondria Resorts to MitoCPR
All mitochondrial functions rely on import of proteins into the organelle because the mitochondrial proteome is almost exclusively encoded by...
Minimally Invasive Microbiopsy Could Revolutionise Skin Tests
Minimally Invasive Microbiopsy Could Revolutionise Skin Tests
Skin biopsy is one of the most essential techniques in dermatology for accurate diagnosis of neoplastic or inflammatory...
ddPCR Facilitates Highly Sensitive, Accurate Detection of Hepatitis B
ddPCR Facilitates Highly Sensitive, Accurate Detection of Hepatitis B
More than 20 billion people worldwide have been infected with hepatitis B virus (HBV), and HBV...
Study Elucidates Role of Soluble Antibodies in Tumor Progression
Study Elucidates Role of Soluble Antibodies in Tumor Progression
A critical part of the immune response system, immunoglobulins occur in two main forms: soluble antibodies...
CRISPR + Gene Delivery System Engenders Versatile Tumor Model
CRISPR + Gene Delivery System Engenders Versatile Tumor Model
A current high priority in cancer research is to functionally validate candidate genetic alterations that are...
Scope of CRISPR? Will it Revolutionize Humanity as Touted?
Scope of CRISPR
Okay so as to justify the hype of the title of this piece, let’s begin at the beginning of CRISPR (no pun...
Biomarkers Could Help Predict Recurrence of Malignant Brain Tumor
Biomarkers Could Help Predict Recurrence of Malignant Brain Tumor
Glioblastoma (GBM) is a highly aggressive brain cancer and accounts for 46.6% of primary malignant brain...
Biotecnika Times – Newsletter 12.04.2018 – DBT Programme for Women Scientists
Biotecnika Times - DBT Programme for Women Scientists
DBT India BioCARe Programme for Women Scientists
Great opportunity for women scientist via DBT India. BioCARe Programme for Women...
Scientists Unveil New Bioengineering Tech to Manufacture Complex Medicines
New Bioengineering Tech to Manufacture Complex Medicines
Microbial biosynthesis of plant natural products from simple building blocks is a promising approach toward scalable production and...
Non-Invasive Portable Device Allows WBC Levels Estimation in Chemotherapy Patients
Non-Invasive Device Allows WBC Levels Estimation in Chemo Patients
White-blood-cell (WBC) status is used as one indicator of immunological status in the diagnosis and treatment...
ILS – Institute of Life Sciences, Bhubaneswar – PhD Admission 2018
ILS - Institute of Life Sciences, Bhubaneswar - PhD Admission 2018
ILS - Institute of Life Sciences, Bhubaneswar has announced PhD admissions for 2018. M.Sc. /...
Stronger but Fewer Neutrophils Could Help Battle Superbugs
Stronger but Fewer Neutrophils Could Help Battle Superbugs
The significance of developing host-modulating personalized therapies to counteract the growing threat of antimicrobial resistance is well-recognized...